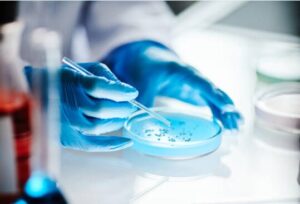

We mention “bad actors” frequently on our website because there are so many of them in the industrialized food supply. It is our goal to raise awareness about this fact so that we might contribute to improving your health. To better understand what these bad actors are and why they are a problem, keep reading.
Gluten is a blessing and a curse. It is responsible for giving bread and other baked goods their wonderfully chewy, elastic texture. However, recent evidence tells us that it is also very difficult to digest and responsible for immune activation and leaky gut in many individuals.

Gluten works in bread by forming
an elastic web, which traps air and carbon dioxide during baking, leading to a fluffy, squishy lattice. This makes for fantastic texture in baked goods. Just think of a fresh-baked, still steaming roll.
Gluten works in your small intestine by binding to special receptors that signal a hormone to loosen the tight junctions between the cells there. This makes for less-than-fantastic opportunities for gluten and the other bad actors to trigger an immune response, causing damage to your cells. Just think of bloating, indigestion and gut pain.
The long-term effects of gluten exposure are worse than indigestion and gut pain, though. Researchers have theorized that repeatedly weakening the tight junctions of your gut by exposing it to gluten almost continually could be one of the steps to autoimmune diseases.
Plant lectins are a blessing for plants but a curse for all of us. Lectins are found in nearly 40% of the American food supply but wheat is the worst source. Plants evolved these lectins to work as deterrents to their predators.

They are proteins that are really good at sticking to the sugars in our cells. After they are good and stuck, they can actually destroy the cells they are stuck to. Just like gluten, this creates opportunity for lectins and other bad actors to get past the wall and into the bloodstream
Again, researchers fear that over time and with repeated exposure, this weakening of the integrity of the gut wall could open the door for chronic inflammatory and autoimmune diseases. We call lectins ninjas because they have been secretly assassinating cells in our gut for a long time. The science shining a light on these ninjas is called lectinology and is relatively new. Lectinology has found that we can protect ourselves from these ninjas by using decoy sugars.
Our bodies are home to billions of bacteria and yeast all of the time. Most of the time, they are helping us by digesting things that we can’t, making vitamins, and boosting our immune system. Sometimes, however, certain yeast and bacteria can get out of control and cause problems. Think of the situation like a house party.
Lots of people are there and most of them are having a great time and improving the atmosphere with their jolliness and good mood. But there are always a few people at parties that just have to take it too far. They drink too much, they make too much noise, they go into parts of the house you asked them not to and sometimes they break stuff. Your gut is just like that – most of the yeast and bacteria are there having a great time and making the place better but there are a few of the party goers that will take it too far if given the chance.
A way to prevent this is by taking a high quality probiotic. The term probiotic is a fancy way of saying “good bacteria.” Probiotics are like a really well thought out party invite list. You’re putting only good, well behaved bacteria into your gut so that everyone has a great time and the environment is made better.
It is a little unfair of us to call these bad actors because they are just foods that are minding their own business but accidentally find themselves where they are not wanted. The immune system is not particularly understanding about things being where they are not supposed to be in the body. Undigested foods that stumble through the holes in a leaky gut get treated just like any other invader.

Fats, carbohydrates, and proteins need to be broken down into their building blocks before the body can use them. When gluten or lectins put holes in the wall, sometimes these foods slip through before they are small enough to be used and this can activate the immune system.
There are two good ways to minimize the risk of this happening: heal the gut wall and provide extra enzymes to more quickly break these foods down. Enzymes are chemicals that the body uses to break foods into small enough parts for absorption.
As you know, not all foods are created nutritionally equal. This applies to the digestibility of foods as well. We’ve covered how gluten and lectins are resistant to digestion but they are not the only ones: Lactose, the sugar found in dairy products, and phytate, the storage form of phosphorus in plants, can also be difficult to break down.

Etiam magna arcu, ullamcorper ut pulvinar et, ornare sit amet ligula. Aliquam vitae bibendum lorem. Cras id dui lectus.
63739 street lorem ipsum City, Country
+12 (0) 345 678 9
info@company.com

Take the first step towards a happier gut. Get 5% OFF your next purchase of DigestShield.